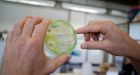

Also see the CKA News Wall
NEWS IMAGE COLLAGE / for 04-2017
 Russian think-tank drew up plan to sway 2016 election, U.S. officials say
Russian think-tank drew up plan to sway 2016 election, U.S. officials say
A Russian government think-tank controlled by Vladimir Putin developed a plan to swing the 2016 U.S. presidential election to Donald Trump and undermine voters' faith in the American electoral system, according to three current and four former U.S. offici
| Posted: | 7:21 AM on Thursday |
| Topic: | Uncle Sam |
| Hits: | 207390 |
| Rating: | 20740 |
| Poster: | Robair |
 As coral reefs die, huge swaths of the ocean floor are eroding along with them
As coral reefs die, huge swaths of the ocean floor are eroding along with them
U.S. government scientists have found a dramatic impact from the continuing decline of coral reefs: The seafloor around them is eroding and sinking, deepening coastal waters and exposing nearby communities to damaging waves that reefs used to weaken.
| Posted: | 7:01 AM on Thursday |
| Topic: | Environmental |
| Hits: | 206748 |
| Rating: | 20675 |
| Poster: | DrCaleb |
Canadian researchers discover new drug to fight antibiotic-resistant infections
Canadian researchers discover new drug to fight antibiotic-resistant infections
Two scientists at St. Boniface Hospital in Winnipeg have discovered a brand new way of killing invasive bacteria and, if approved, it promises minimal side effects for patients.
| Posted: | 7:00 AM on Thursday |
| Topic: | Health |
| Hits: | 207394 |
| Rating: | 20739 |
| Poster: | DrCaleb |
 South Indian frog oozes molecule that inexplicably decimates flu viruses | Ars Technica
South Indian frog oozes molecule that inexplicably decimates flu viruses | Ars Technica
| Posted: | 6:18 AM on Thursday |
| Topic: | Science |
| Hits: | 207508 |
| Rating: | 20751 |
| Poster: | DrCaleb |
 What a Trip: First Evidence for Higher State of Consciousness Found
What a Trip: First Evidence for Higher State of Consciousness Found
| Posted: | 6:16 AM on Thursday |
| Topic: | Health |
| Hits: | 207046 |
| Rating: | 20705 |
| Poster: | DrCaleb |

For Carson Morin, it was all about the money. And he wanted to make a lot of it by running a network of strippers.
| Posted: | 1:07 AM on Thursday |
| Topic: | Law & Order |
| Hits: | 206730 |
| Rating: | 20673 |
| Poster: | N_Fiddledog |

The beloved polar bear, Szenja, has died unexpectedly at SeaWorld in San Diego at the age of 21. Caregivers say she had a loss of appetite and energy for about a week before she died.
| Posted: | 1:05 AM on Thursday |
| Topic: | Lifestyle |
| Hits: | 207428 |
| Rating: | 20744 |
| Poster: | N_Fiddledog |
 Umbilical cord blood from babies could help bring back memory for dementia patients
Umbilical cord blood from babies could help bring back memory for dementia patients
Dementia patients have been offered hope that their memory could be repaired after scientists showed that injecting blood from the umbilical cords of human babies restores brain function.
| Posted: | 12:41 AM on Thursday |
| Topic: | Health |
| Hits: | 207301 |
| Rating: | 20730 |
| Poster: | N_Fiddledog |
 Prattville High student gets one-year expulsion for water gun incident
Prattville High student gets one-year expulsion for water gun incident
| Posted: | 12:36 AM on Thursday |
| Topic: | Uncle Sam |
| Hits: | 207057 |
| Rating: | 20706 |
| Poster: | N_Fiddledog |
 LGBTQ police officers' group calls it 'unacceptable' for city to fund Pride
LGBTQ police officers' group calls it 'unacceptable' for city to fund Pride
| Posted: | 12:33 AM on Thursday |
| Topic: | Lifestyle |
| Hits: | 207542 |
| Rating: | 20754 |
| Poster: | N_Fiddledog |
 Ann Coulter Vows to Speak at Berkeley After University Cancels Her Appearance
Ann Coulter Vows to Speak at Berkeley After University Cancels Her Appearance
"Yes, it was officially banned," said the political commentator and author. "But they can't stop me. I'm an American. I have constitutional rights."
| Posted: | 12:32 AM on Thursday |
| Topic: | Lifestyle |
| Hits: | 207171 |
| Rating: | 20717 |
| Poster: | N_Fiddledog |
 Driving to the top of the world: Exploring Canada's new Arctic highway
Driving to the top of the world: Exploring Canada's new Arctic highway
| Posted: | 5:02 PM on Wednesday |
| Topic: | Misc CDN |
| Hits: | 207510 |
| Rating: | 20751 |
| Poster: | Hyack |
 Accused polygamists plead not guilty in trial testing the limit of religious freedoms in Canada
Accused polygamists plead not guilty in trial testing the limit of religious freedoms in Canada
Two leaders of a fundamentalist sect that condones plural marriage have pleaded not guilty to polygamy charges in a Cranbrook, B.C., courtroom where an epic battle to test the limits of religious freedom in Canada is playing out.
| Posted: | 8:59 AM on Wednesday |
| Topic: | Religion |
| Hits: | 207670 |
| Rating: | 20767 |
| Poster: | N_Fiddledog |
 Why did the Liberals in leaky old Ottawa get so angry about shipbuilding stories'
Why did the Liberals in leaky old Ottawa get so angry about shipbuilding stories'
One of the most curious aspects of the criminal investigation involving Vice-Admiral Mark Norman is the notion that one particular leak, involving the navy's deal to acquire a temporary supply ship, stood out among all of the other leaks that flood Canada
| Posted: | 7:05 AM on Wednesday |
| Topic: | Military |
| Hits: | 207504 |
| Rating: | 20750 |
| Poster: | DrCaleb |
 Lone challenger of 7-term Alberta chief plans legal action after being stripped from ballot
Lone challenger of 7-term Alberta chief plans legal action after being stripped from ballot
The only would-be challenger for chief of O'Chiese First Nation plans to take his case to federal court after he was disqualified as a candidate under new election rules that also make it nearly impossible for him to challenge the decision.
| Posted: | 7:02 AM on Wednesday |
| Topic: | Political |
| Hits: | 207083 |
| Rating: | 20708 |
| Poster: | DrCaleb |
 Canada will legalize pot, after arresting a bunch of people for pot offences first: Neil Macdonald
Canada will legalize pot, after arresting a bunch of people for pot offences first: Neil Macdonald
Why the government cannot simply decide to invoke prosecutorial and police discretion, and cease enforcing the cannabis laws it considers unjust, was not explained. Why that would necessarily be a "free for all" also went unexplained.
| Posted: | 6:56 AM on Wednesday |
| Topic: | Law & Order |
| Hits: | 207071 |
| Rating: | 20707 |
| Poster: | DrCaleb |
 Driving to the top of the world: Exploring Canada's new Arctic highway
Driving to the top of the world: Exploring Canada's new Arctic highway
| Posted: | 6:42 AM on Wednesday |
| Topic: | Provincial Politics |
| Hits: | 207454 |
| Rating: | 20745 |
| Poster: | DrCaleb |
 Edmonton Catholic school board wants mandatory vaccinations for all Alberta students
Edmonton Catholic school board wants mandatory vaccinations for all Alberta students
Edmonton Catholic Schools is calling on the province to make vaccines mandatory for students attending all publicly funded schools.
| Posted: | 6:40 AM on Wednesday |
| Topic: | Health |
| Hits: | 207132 |
| Rating: | 20713 |
| Poster: | DrCaleb |
 Dairy Farmers of Manitoba shoot back at Trump after he calls out Canadian industry
Dairy Farmers of Manitoba shoot back at Trump after he calls out Canadian industry
The Dairy Farmers of Manitoba took exception to a fiery trade speech from U.S. President Donald Trump on Tuesday.
| Posted: | 6:39 AM on Wednesday |
| Topic: | Business |
| Hits: | 207122 |
| Rating: | 20712 |
| Poster: | DrCaleb |
 Human smuggling charge laid in case of asylum seekers crossing Sask. border
Human smuggling charge laid in case of asylum seekers crossing Sask. border
RCMP say a human smuggling charge has been laid in relation to asylum seekers who were attempting to cross the U.S. border into Saskatchewan.
| Posted: | 6:15 AM on Wednesday |
| Topic: | Law & Order |
| Hits: | 206999 |
| Rating: | 20700 |
| Poster: | DrCaleb |
 8 months pregnant, Moncton runner finishes Boston Marathon
8 months pregnant, Moncton runner finishes Boston Marathon
Running the Boston Marathon was on Julie McGivery's bucket list, although crossing the finish line while 32 weeks pregnant was not the way she planned to do it.
| Posted: | 8:49 PM on Tuesday |
| Topic: | Sports |
| Hits: | 207357 |
| Rating: | 20736 |
| Poster: | Hyack |
 Massive iceberg on Newfoundland's Southern Shore attracts shutterbugs
Massive iceberg on Newfoundland's Southern Shore attracts shutterbugs
Traffic snarled as gawkers flood Newfoundland's Southern Shore to snap photos of an iceberg stuck in shallow waters. The highest point of the iceberg measures roughly 46 metres.
| Posted: | 8:47 PM on Tuesday |
| Topic: | Misc CDN |
| Hits: | 207128 |
| Rating: | 20713 |
| Poster: | Hyack |
 'Too close for comfort': Former Olympian home after being surrounded by wolves on remote lake
'Too close for comfort': Former Olympian home after being surrounded by wolves on remote lake
| Posted: | 6:26 PM on Tuesday |
| Topic: | Misc CDN |
| Hits: | 207060 |
| Rating: | 20706 |
| Poster: | Hyack |
 Prince Charles, Camilla plan visit to celebrate Canada's 150th birthday
Prince Charles, Camilla plan visit to celebrate Canada's 150th birthday
Prince Charles and his wife Camilla will make a three-day royal visit to help celebrate Canada's 150th anniversary of Confederation. Gov. Gen. David Johnston announced the Prince of Wales and the Duchess of Cornwall will be here from June 29 to July 1.
| Posted: | 6:19 PM on Tuesday |
| Topic: | Misc CDN |
| Hits: | 207005 |
| Rating: | 20701 |
| Poster: | Hyack |
 Approval of Mount Polley mine waste dumping irks critics
Approval of Mount Polley mine waste dumping irks critics
Mount Polley Mining Corporation has been granted permission to drain treated mining waste water into Quesnel Lake, a glacial lake providing drinking water to residents of Likely B.C., north-east of Williams Lake.
| Posted: | 6:13 PM on Tuesday |
| Topic: | Environmental |
| Hits: | 206900 |
| Rating: | 20690 |
| Poster: | Hyack |
 Asteroid to make close pass to Earth on Wednesday
Asteroid to make close pass to Earth on Wednesday
| Posted: | 6:12 PM on Tuesday |
| Topic: | Misc World |
| Hits: | 206850 |
| Rating: | 20685 |
| Poster: | Hyack |
 Vimy gunner's dog tags found in French garden 100 years after death
Vimy gunner's dog tags found in French garden 100 years after death
On the 100th anniversary of the Battle of Vimy Ridge, former Cambridge, Ont., resident Cynthia Kerr found an online post from a man who said he'd dug up her uncle's First World War dog tags in his garden in France.
| Posted: | 6:09 PM on Tuesday |
| Topic: | History |
| Hits: | 207546 |
| Rating: | 20755 |
| Poster: | Hyack |
 Edmonton helicopter squad heads to Iraq to replace Quebec squadron
Edmonton helicopter squad heads to Iraq to replace Quebec squadron
The Canadian military has deployed 60 members of an Edmonton-based helicopter squadron to Iraq as part of Operation Impact, a mission to fight Islamic State militants in the country's north.
| Posted: | 4:28 PM on Tuesday |
| Topic: | Military |
| Hits: | 207540 |
| Rating: | 20755 |
| Poster: | Hyack |
 Canadian soldiers were key to Korean War but doubts Canada will intervene now
Canadian soldiers were key to Korean War but doubts Canada will intervene now
As tensions escalate in the Korean Peninsula, some are asking whether Canadians could play a role like they did 66 years ago in the battle of Kapyong, when they kept the South Korean city of Seoul from falling back into North Korean hands.
| Posted: | 4:26 PM on Tuesday |
| Topic: | Misc World |
| Hits: | 206958 |
| Rating: | 20696 |
| Poster: | Hyack |
 Playing outside can build children's connection to nature, author says
Playing outside can build children's connection to nature, author says
Scott Sampson, Science World CEO and author of 'How to Raise a Wild Child', says kids who don't play outside are emotionally disconnected from nature.
| Posted: | 4:23 PM on Tuesday |
| Topic: | Lifestyle |
| Hits: | 207323 |
| Rating: | 20732 |
| Poster: | Hyack |
 'It scares me': Permafrost thaw in Canadian Arctic sign of global trend
'It scares me': Permafrost thaw in Canadian Arctic sign of global trend
For years now, buildings in Inuvik have been sinking due to thawing permafrost. It's part of a worrying trend across the Arctic, writes David Michael Lamb.
| Posted: | 4:21 PM on Tuesday |
| Topic: | Environmental |
| Hits: | 207461 |
| Rating: | 20747 |
| Poster: | Hyack |
 Dramatic rescue saves 7 horses from icy death in frozen-over slough
Dramatic rescue saves 7 horses from icy death in frozen-over slough
Firefighters near Grande Prairie, Alta., used their specialized training to rescue 10 frantic horses that broke through an ice-covered slough on Sunday.
| Posted: | 4:20 PM on Tuesday |
| Topic: | Misc CDN |
| Hits: | 207266 |
| Rating: | 20728 |
| Poster: | Hyack |
 Liftoff: University of Alberta satellite rockets into orbit
Liftoff: University of Alberta satellite rockets into orbit
With an explosion of rocket fuel and plume of smoke, a tiny satellite made by a group of Edmonton students has begun its journey, while propelling Alberta into the space industry.
| Posted: | 4:19 PM on Tuesday |
| Topic: | Tech |
| Hits: | 206886 |
| Rating: | 20689 |
| Poster: | Hyack |
 Sask. ranchers stunned as beaver herds 150 cattle
Sask. ranchers stunned as beaver herds 150 cattle
Curious heifers marched after beaver, rancher calls event a very Canadian moment. Rancher Adrienne Ivey may have heard of a beaver, but until now, had never seen a beaver herd. Cattle, that is.
| Posted: | 4:16 PM on Tuesday |
| Topic: | Strange |
| Hits: | 207274 |
| Rating: | 20727 |
| Poster: | Hyack |
 USS Arizona survivor laid to rest inside sunken battleship
USS Arizona survivor laid to rest inside sunken battleship
A USS Arizona sailor who survived the attack on Pearl Harbor was laid to inside the ship he escaped. The remains of Retired Master Chief Petty Officer Raymond Haerry, 94, were interred inside the h...
| Posted: | 10:52 AM on Tuesday |
| Topic: | Military |
| Hits: | 208049 |
| Rating: | 20806 |
| Poster: | xerxes |
 The IMF is nowhere near as optimistic about our economy as the Bank of Canada is | Financial Post
The IMF is nowhere near as optimistic about our economy as the Bank of Canada is | Financial Post
The Washington-based organization continues to estimate Canada's gross domestic product will grow by 1.9% this year, unchanged from its previous forecast
| Posted: | 10:53 AM on Tuesday |
| Topic: | Economics |
| Hits: | 207602 |
| Rating: | 20760 |
| Poster: | shockedcanadian |
 Spicer briefings a ratings juggernaut, TMZ dubs him 'most visible'
Spicer briefings a ratings juggernaut, TMZ dubs him 'most visible'
There's a reason why TMZ's Harvey Levin recently called White House spokesman Sean Spicer one of the most visible people in all of Washington.
| Posted: | 10:06 AM on Tuesday |
| Topic: | Political |
| Hits: | 207065 |
| Rating: | 20707 |
| Poster: | N_Fiddledog |
 The purge of a report on radical Islam has put NYC at risk
The purge of a report on radical Islam has put NYC at risk
The NYPD has had a stellar track record of protecting the city from another 9/11, foiling more than 20 planned terrorist attacks since 2001. But some worry the department is losing its terror-fighting edge as it tries to please Muslim grievance groups.
| Posted: | 9:56 AM on Tuesday |
| Topic: | Uncle Sam |
| Hits: | 207085 |
| Rating: | 20709 |
| Poster: | N_Fiddledog |
 Canada glacier melt rerouted in rare case of 'river piracy'
Canada glacier melt rerouted in rare case of 'river piracy'
Scientists have witnessed the first modern case of what they call "river piracy" and they blame global warming. Most of the water gushing from a large glacier in northwest Canada last year suddenly switched from one river to another.
| Posted: | 7:25 AM on Tuesday |
| Topic: | Environmental |
| Hits: | 206777 |
| Rating: | 20678 |
| Poster: | DrCaleb |
 Robert Taylor, innovator who shaped modern computing, dies
Robert Taylor, innovator who shaped modern computing, dies
| Posted: | 7:24 AM on Tuesday |
| Topic: | Tech |
| Hits: | 207025 |
| Rating: | 20703 |
| Poster: | DrCaleb |
 May to seek snap UK election for 8 June
May to seek snap UK election for 8 June
UK PM Theresa May announces plan to call snap general election on 8 June
| Posted: | 3:46 AM on Tuesday |
| Topic: | Misc World |
| Hits: | 206803 |
| Rating: | 20680 |
| Poster: | martin14 |
 Afghan interpreter seeks safety in Canada
Afghan interpreter seeks safety in Canada
| Posted: | 3:15 PM on Monday |
| Topic: | Misc CDN |
| Hits: | 207057 |
| Rating: | 20706 |
| Poster: | N_Fiddledog |
 B.C. Green Party candidate says he regrets impersonating Martin Luther King during rally
B.C. Green Party candidate says he regrets impersonating Martin Luther King during rally
Green Party candidate Mark Neufeld says he regrets imitating Martin Luther King during a campaign rally.
| Posted: | 3:14 PM on Monday |
| Topic: | Provincial Politics |
| Hits: | 207474 |
| Rating: | 20747 |
| Poster: | N_Fiddledog |

| Posted: | 12:18 AM on Monday |
| Topic: | Uncle Sam |
| Hits: | 207359 |
| Rating: | 20736 |
| Poster: | N_Fiddledog |
 Sainsbury's and Asda won't stock Christian Easter egg
Sainsbury's and Asda won't stock Christian Easter egg
Two of the four big supermarket chains have refused to stock a Christian Easter egg that tells the story of Jesus - despite stocking a Halal Easter egg (pictured).
| Posted: | 3:50 PM on Sunday |
| Topic: | Religion |
| Hits: | 211597 |
| Rating: | 21160 |
| Poster: | N_Fiddledog |
 Cleveland police seek suspect in Facebook homicide video
Cleveland police seek suspect in Facebook homicide video
Cleveland Police are seeking a suspect who posted video of a homicide on Facebook, authorities said.
| Posted: | 3:28 PM on Sunday |
| Topic: | Law & Order |
| Hits: | 206706 |
| Rating: | 20671 |
| Poster: | N_Fiddledog |
 Husband & wife shocked after DNA test reveals they are twins
Husband & wife shocked after DNA test reveals they are twins
| Posted: | 5:44 AM on Sunday |
| Topic: | Strange |
| Hits: | 207860 |
| Rating: | 20786 |
| Poster: | BeaverFever |
 Bloody brawls erupt at Trump rallies in Berkeley
Bloody brawls erupt at Trump rallies in Berkeley
| Posted: | 12:17 AM on Sunday |
| Topic: | Uncle Sam |
| Hits: | 207492 |
| Rating: | 20749 |
| Poster: | N_Fiddledog |

| Posted: | 10:51 PM on Saturday |
| Topic: | Political |
| Hits: | 207040 |
| Rating: | 20704 |
| Poster: | Freakinoldguy |
 NSA's powerful Windows hacking tools leaked online
NSA's powerful Windows hacking tools leaked online
A hacking group has dumped a collection of spy tools allegedly used by the National Security Agency online. Experts say they are damaging.
| Posted: | 12:32 AM on Saturday |
| Topic: | Tech |
| Hits: | 207239 |
| Rating: | 20724 |
| Poster: | N_Fiddledog |
 Richard Fochtmann, Maine Democrats at 'Values and Vision' meeting laugh at white male suicide
Richard Fochtmann, Maine Democrats at 'Values and Vision' meeting laugh at white male suicide
A Maine-based website has released cellphone video of Democrats at a "Values and Vision" community meeting laughing at suicide among America's white male population.
| Posted: | 12:27 AM on Saturday |
| Topic: | Lifestyle |
| Hits: | 209394 |
| Rating: | 20939 |
| Poster: | N_Fiddledog |
 US-led airstrike kills 18 'friendly fighters' in Syria
US-led airstrike kills 18 'friendly fighters' in Syria
An airstrike accidentally targeted a Syrian Democratic Forces unit which was battling the terror group south of Tabqa.
| Posted: | 12:21 AM on Saturday |
| Topic: | Military |
| Hits: | 207170 |
| Rating: | 20717 |
| Poster: | N_Fiddledog |

Authorities say a man packing a blue light and a BB gun pulled over a non-descript car on Interstate 95, ready to play "traffic cop" again.
| Posted: | 12:19 AM on Saturday |
| Topic: | Law & Order |
| Hits: | 207025 |
| Rating: | 20703 |
| Poster: | N_Fiddledog |
 Marine Le Pen facing wipe out in French election after COMPUTER BLUNDER
Marine Le Pen facing wipe out in French election after COMPUTER BLUNDER
A MONUMENTAL computer blunder could cost Marine Le Pen the French general election as 500,000 citizens living outside of France have the chance to vote twice.
| Posted: | 12:18 AM on Saturday |
| Topic: | Misc World |
| Hits: | 207059 |
| Rating: | 20706 |
| Poster: | N_Fiddledog |
 Utah judge at rape sentencing: Ex-Mormon bishop a 'good man'
Utah judge at rape sentencing: Ex-Mormon bishop a 'good man'
| Posted: | 12:16 AM on Saturday |
| Topic: | Law & Order |
| Hits: | 208281 |
| Rating: | 20828 |
| Poster: | N_Fiddledog |
 Russia, Iran and Syria issue warning to U.S.
Russia, Iran and Syria issue warning to U.S.
Russia, Syria and Iran strongly warned the United States Friday against launching new strikes on Syria and called for an international investigation of the chemical weapons attack there that killed nearly 90 people.
| Posted: | 4:18 PM on Friday |
| Topic: | Misc World |
| Hits: | 207068 |
| Rating: | 20707 |
| Poster: | Hyack |
 Polar bear, monarch butterfly among 517 species on Canada's latest at-risk list
Polar bear, monarch butterfly among 517 species on Canada's latest at-risk list
Polar bears and the Canadian monarch butterfly have been added to an international list of species and subspecies that are at risk of disappearing entirely from the planet.
| Posted: | 4:17 PM on Friday |
| Topic: | Environmental |
| Hits: | 207513 |
| Rating: | 20752 |
| Poster: | Hyack |
 N. Korean official: Ready for war if Trump wants it
N. Korean official: Ready for war if Trump wants it
U.S. President Donald Trump's tweets are adding fuel to a "vicious cycle" of tensions on the Korean Peninsula, North Korea's vice foreign minister told The Associated Press in an exclusive interview Friday. The official added that if the U.S. shows any si
| Posted: | 4:13 PM on Friday |
| Topic: | Misc World |
| Hits: | 207026 |
| Rating: | 20703 |
| Poster: | Hyack |
 Next-generation U.S. aircraft carrier: builder's sea trials done
Next-generation U.S. aircraft carrier: builder's sea trials done
A shipbuilder says the USS Gerald R. Ford, the first of the Navy's next generation of aircraft carriers, has completed the builder's sea trials.
| Posted: | 4:00 PM on Friday |
| Topic: | Military |
| Hits: | 207384 |
| Rating: | 20738 |
| Poster: | Hyack |
 Massive bomb drop by U.S. killed 36 militants, Afghan officials say
Massive bomb drop by U.S. killed 36 militants, Afghan officials say
The biggest non-nuclear bomb ever dropped in combat by the U.S. military killed 36 militants in eastern Afghanistan, officials said Friday, and villagers in the remote, mountainous area described being terrified by the "earsplitting blast."
| Posted: | 3:59 PM on Friday |
| Topic: | Misc World |
| Hits: | 206944 |
| Rating: | 20694 |
| Poster: | Hyack |
 Researchers find 'night owl' gene variant
Researchers find 'night owl' gene variant
If you can't get to sleep at a reasonable hour and dread your alarm clock going off each morning, it could be in your genes.
| Posted: | 3:50 PM on Friday |
| Topic: | Health |
| Hits: | 207259 |
| Rating: | 20726 |
| Poster: | Hyack |
 Bow Valley wolf pack down to 2 after male killed by hunters in B.C.
Bow Valley wolf pack down to 2 after male killed by hunters in B.C.
A wildlife specialist in Banff National Park has hopes the Bow Valley wolf pack will recover after one of its three members was shot and killed by a hunter in B.C. last month.
| Posted: | 3:43 PM on Friday |
| Topic: | Environmental |
| Hits: | 207032 |
| Rating: | 20703 |
| Poster: | Hyack |
 Massive chicken egg cracked open to reveal another egg inside
Massive chicken egg cracked open to reveal another egg inside
A hen's egg that was more than three times the size of a normal egg has been cracked open. The results are amazing.
| Posted: | 3:35 PM on Friday |
| Topic: | Strange |
| Hits: | 207549 |
| Rating: | 20755 |
| Poster: | Hyack |
 Canadian Rangers kick off northern adventure to mark Canada's 150th
Canadian Rangers kick off northern adventure to mark Canada's 150th
All 60 Ranger patrols in the North are relaying a baton, actually a double-bladed axe, across north from Yukon to Nunavut then back to Yellowknife.
| Posted: | 3:24 PM on Friday |
| Topic: | Military |
| Hits: | 207110 |
| Rating: | 20711 |
| Poster: | Hyack |
 Border services officer assaulted by asylum seeker who was detained for criminal past
Border services officer assaulted by asylum seeker who was detained for criminal past
Nearly half of the asylum seekers crossing the Manitoba border illegally in the last few weeks are being detained because of serious criminal records, says the union representing border patrol officers. One assaulted a female CBSA officer as he was being
| Posted: | 1:15 PM on Friday |
| Topic: | Law & Order |
| Hits: | 206892 |
| Rating: | 20689 |
| Poster: | N_Fiddledog |
 Trump Signs Law Giving States Option To Deny Funding For Planned Parenthood
Trump Signs Law Giving States Option To Deny Funding For Planned Parenthood
The legislation rolls back an Obama-era rule that prohibited states from withholding certain federal funds from organizations that provide legal abortions.
| Posted: | 1:08 PM on Friday |
| Topic: | Uncle Sam |
| Hits: | 207083 |
| Rating: | 20708 |
| Poster: | N_Fiddledog |

With 53 broadcast shows not yet renewed, a LOT of programs could get the ax over the next month. Which shows will come back? Which will the networks bury? We spoke to industry insiders to get the scoop and have ranked all the limbo shows from safest to de
| Posted: | 1:00 PM on Friday |
| Topic: | Arts & Entertainment |
| Hits: | 207471 |
| Rating: | 20747 |
| Poster: | N_Fiddledog |
 Fugitive who mailed manifesto to Trump captured in Wisconsin
Fugitive who mailed manifesto to Trump captured in Wisconsin
Joseph Jakubowski allegedly stole 18 firearms from a gun store on April 4.
| Posted: | 12:47 PM on Friday |
| Topic: | Law & Order |
| Hits: | 206849 |
| Rating: | 20685 |
| Poster: | N_Fiddledog |
 Immigration arrests at Mexican border continue to plummet
Immigration arrests at Mexican border continue to plummet
Arrests of people caught trying to sneak into the United States across the Mexican border plummeted...
| Posted: | 12:43 PM on Friday |
| Topic: | Uncle Sam |
| Hits: | 207009 |
| Rating: | 20701 |
| Poster: | N_Fiddledog |
 Leland Officer Jacob Schwenk Shot 6 Times, Fights Back, Takes Shooter Out
Leland Officer Jacob Schwenk Shot 6 Times, Fights Back, Takes Shooter Out
WECT News has obtained dashcam video of the officer-involved shooting on the night of December 9, 2016, that resulted in Officer Jacob Schwenk of the Leland Police Department nearly losing his life...
| Posted: | 12:41 PM on Friday |
| Topic: | Law & Order |
| Hits: | 206890 |
| Rating: | 20689 |
| Poster: | N_Fiddledog |
 Fast and Furious scandal: Suspected triggerman in border agent's murder arrested
Fast and Furious scandal: Suspected triggerman in border agent's murder arrested
The cartel member suspected of shooting and killing U.S. Border Patrol agent Brian Terry in 2010 with a gun supplied by the U.S. government was arrested in Mexico Wednesday, senior law enforcement, Border Patrol, and congressional sources told Fox News.
| Posted: | 2:42 PM on Thursday |
| Topic: | Uncle Sam |
| Hits: | 207165 |
| Rating: | 20717 |
| Poster: | N_Fiddledog |
 Detroit Doctor Accused Of Female Genital Mutilation Of Young Girls
Detroit Doctor Accused Of Female Genital Mutilation Of Young Girls
Detroit, MI - The case accusing the doctor of "barbaric" practice may be the first in the United States, the federal government said.
| Posted: | 2:38 PM on Thursday |
| Topic: | Health |
| Hits: | 206919 |
| Rating: | 20692 |
| Poster: | N_Fiddledog |
 Police Call Qurans Found in Toilet at UTD 'Shocking and Unusual'
Police Call Qurans Found in Toilet at UTD 'Shocking and Unusual'
Police at the University of Texas at Dallas say they're searching for the person who dumped several copies of the Quran in campus toilets -- in an incident they call "shocking" and "unusual."
| Posted: | 11:50 AM on Thursday |
| Topic: | Religion |
| Hits: | 207744 |
| Rating: | 20773 |
| Poster: | N_Fiddledog |
 U.S. drops 'mother of all bombs' in Afghanistan, aiming for ISIS caves
U.S. drops 'mother of all bombs' in Afghanistan, aiming for ISIS caves
The United States dropped a massive GBU-43 bomb, also known as the "mother of all bombs," in eastern Afghanistan on Thursday against a series of caves used by ISIS militants, the military said.
| Posted: | 11:44 AM on Thursday |
| Topic: | Military |
| Hits: | 207855 |
| Rating: | 20787 |
| Poster: | Robair |
 US Expected to Return 4,000 Somali Migrants to Their Homeland
US Expected to Return 4,000 Somali Migrants to Their Homeland
Somali ambassador says officials are preparing lists of those who will be deported; most deportations involve those who applied for asylum but were rejected
| Posted: | 11:11 AM on Thursday |
| Topic: | Misc World |
| Hits: | 206738 |
| Rating: | 20674 |
| Poster: | N_Fiddledog |
 8-year-old boy drives 4-year-old sister to get cheeseburger: Police
8-year-old boy drives 4-year-old sister to get cheeseburger: Police
EAST PALESTINE, Ohio- It wasn't a Big Mac attack, but a craving for the 'Golden Arches' that ended with a little boy taking his young sister for a ride in his dad's van.
| Posted: | 10:12 AM on Thursday |
| Topic: | Strange |
| Hits: | 207646 |
| Rating: | 20766 |
| Poster: | N_Fiddledog |
 ISIS cuts EARS off 33 fighters who fled battle in Mosul
ISIS cuts EARS off 33 fighters who fled battle in Mosul
ISIS is now cutting the ears off fighters caught fleeing battles in Iraq, a source has said, abandoning its old practice of executing deserters because they are short of men.
| Posted: | 9:54 AM on Thursday |
| Topic: | Misc World |
| Hits: | 206990 |
| Rating: | 20699 |
| Poster: | N_Fiddledog |

FRANCE will have a referendum on whether to stay in the European Union six months after the presidential election should Marine Le Pen win, the Front National leader has claimed.
| Posted: | 9:45 AM on Thursday |
| Topic: | Misc World |
| Hits: | 206766 |
| Rating: | 20677 |
| Poster: | N_Fiddledog |
 Since Wynne became premier number of teachers on Sunshine List nearly tripled, costing taxpayers $765M
Since Wynne became premier number of teachers on Sunshine List nearly tripled, costing taxpayers $765M
| Posted: | 9:44 AM on Thursday |
| Topic: | Provincial Politics |
| Hits: | 207218 |
| Rating: | 20722 |
| Poster: | N_Fiddledog |
 Russian Disinformation Technology
Russian Disinformation Technology
| Posted: | 9:14 AM on Thursday |
| Topic: | Tech |
| Hits: | 206910 |
| Rating: | 20691 |
| Poster: | DrCaleb |
 Police warn organized crime, including the Hells Angels, has infiltrated the medical marijuana market
Police warn organized crime, including the Hells Angels, has infiltrated the medical marijuana market
Organized crime groups, including the Hells Angels, have managed to obtain legal personal production licences for medical marijuana, only to turn around and illegally sell the product across the country, CBC news has learned.
| Posted: | 6:52 AM on Thursday |
| Topic: | Law & Order |
| Hits: | 207592 |
| Rating: | 20760 |
| Poster: | Freakinoldguy |
 Banning trans fats in New York led to fewer heart attacks, strokes
Banning trans fats in New York led to fewer heart attacks, strokes
A ban on trans fats in restaurants in New York state has been linked to hundreds of fewer heart attacks and strokes, a new study finds. And as both the U.S. and Canada move to crack down on the artery-cloggers, the findings have the potential to save mill
| Posted: | 6:22 AM on Thursday |
| Topic: | Health |
| Hits: | 207427 |
| Rating: | 20742 |
| Poster: | DrCaleb |
 The deadly toll of B.C.'s stunning backcountry
The deadly toll of B.C.'s stunning backcountry
Alastair Ferries followed footsteps along the edge of a snow ledge near the summit of Mount Harvey struggling to understand when the tracks stopped short.
| Posted: | 4:54 PM on Wednesday |
| Topic: | Misc CDN |
| Hits: | 206840 |
| Rating: | 20684 |
| Poster: | Hyack |
 B.C. paramedics fall short in bid to become an essential service
B.C. paramedics fall short in bid to become an essential service
An attempt by B.C. paramedics to be recognized as an essential service has fallen short. Instead, they will remain under the Health Authorities Act, along with hospital support workers
| Posted: | 4:19 PM on Wednesday |
| Topic: | Health |
| Hits: | 207365 |
| Rating: | 20737 |
| Poster: | Hyack |
 When orcas attack: close encounter with 6 killer whales leaves boaters in awe
When orcas attack: close encounter with 6 killer whales leaves boaters in awe
Elliot Funt was just looking to soak up a little sun in his boat Tuesday but instead the Vancouver man found himself in the middle of a Howe Sound orca storm.
| Posted: | 4:18 PM on Wednesday |
| Topic: | Misc CDN |
| Hits: | 206985 |
| Rating: | 20699 |
| Poster: | Hyack |
 'Acoustic smog' hurting killer whales needs federal action, say scientists
'Acoustic smog' hurting killer whales needs federal action, say scientists
Shipping noise on the B.C. South Coast is already at unsustainable levels for the endangered southern resident killer whales, say scientists, and it's set to increase with the Kinder Morgan Trans Mountain pipeline.
| Posted: | 4:11 PM on Wednesday |
| Topic: | Environmental |
| Hits: | 207291 |
| Rating: | 20730 |
| Poster: | Hyack |

Almost nine out of 10 Canadians are uncomfortable with the idea of deepening economic ties with China, and two-thirds want the Liberal government of Prime Minister Justin Trudeau to tie any future trade deal with Beijing to progress in human rights, accor
| Posted: | 11:46 AM on Wednesday |
| Topic: | Business |
| Hits: | 206927 |
| Rating: | 20693 |
| Poster: | N_Fiddledog |
 We Tracked Every Dollar 235 U.S. Households Spent for a Year, and Found Widespread Financial Vulnerability
We Tracked Every Dollar 235 U.S. Households Spent for a Year, and Found Widespread Financial Vulnerability
| Posted: | 10:29 AM on Wednesday |
| Topic: | Economics |
| Hits: | 207847 |
| Rating: | 20784 |
| Poster: | DrCaleb |
 Condom-clogged pipe leads to prostitution arrests at Austin massage parlor
Condom-clogged pipe leads to prostitution arrests at Austin massage parlor
Austin Police say they have discovered a prostitution ring at a massage parlor in Northwest Austin. They were tipped off about the parlour after a waste pipe became clogged with condoms.
| Posted: | 10:24 AM on Wednesday |
| Topic: | Business |
| Hits: | 207702 |
| Rating: | 20769 |
| Poster: | N_Fiddledog |

| Posted: | 10:13 AM on Wednesday |
| Topic: | Military |
| Hits: | 207264 |
| Rating: | 20726 |
| Poster: | N_Fiddledog |
 Melania Trump accepts damages from Daily Mail over model claims
Melania Trump accepts damages from Daily Mail over model claims
An article published in the newspaper "included false and defamatory claims" about her work as a model, the High Court hears.
| Posted: | 8:15 AM on Wednesday |
| Topic: | Uncle Sam |
| Hits: | 206970 |
| Rating: | 20697 |
| Poster: | N_Fiddledog |
 The 2018 Dodge Challenger SRT Demon is an absolute beast
The 2018 Dodge Challenger SRT Demon is an absolute beast
| Posted: | 8:02 AM on Wednesday |
| Topic: | Uncle Sam |
| Hits: | 207341 |
| Rating: | 20734 |
| Poster: | N_Fiddledog |
 No more tuition tax rebate, but more money for refugee housing coming in Manitoba budget
No more tuition tax rebate, but more money for refugee housing coming in Manitoba budget
The provincial budget will usher in more money for refugee housing, but will usher out the tuition tax rebate, CBC News has learned.
| Posted: | 7:27 AM on Wednesday |
| Topic: | Provincial Politics |
| Hits: | 207406 |
| Rating: | 20741 |
| Poster: | N_Fiddledog |
 Budget bill would allow departments, agencies to avoid using Shared Services Canada
Budget bill would allow departments, agencies to avoid using Shared Services Canada
The Liberals have introduced an omnibus budget bill that includes a measure that would allow government departments and agencies the option of not using Shared Services Canada for some IT equipment and services.
| Posted: | 7:21 AM on Wednesday |
| Topic: | Tech |
| Hits: | 206983 |
| Rating: | 20698 |
| Poster: | DrCaleb |
 Cellphone surveillance technology being used by local police across Canada
Cellphone surveillance technology being used by local police across Canada
| Posted: | 6:38 AM on Wednesday |
| Topic: | Law & Order |
| Hits: | 207039 |
| Rating: | 20704 |
| Poster: | DrCaleb |
 It is rocket science: New details revealed about proposed space port in Nova Scotia
It is rocket science: New details revealed about proposed space port in Nova Scotia
Documents obtained by CBC News reveal new details about a proposed rocket launch facility near Canso, N.S., including plans for a control centre and launch pad, separated by a 2.5-kilometre custom rail track.
| Posted: | 6:15 AM on Wednesday |
| Topic: | Science |
| Hits: | 207399 |
| Rating: | 20740 |
| Poster: | DrCaleb |

| Posted: | 6:13 AM on Wednesday |
| Topic: | Health |
| Hits: | 206809 |
| Rating: | 20681 |
| Poster: | DrCaleb |
 Sessions orders Justice Dept. to end forensic science commission, suspend review policy
Sessions orders Justice Dept. to end forensic science commission, suspend review policy
Attorney General Jeff Sessions will end a Justice Department partnership with independent scientists to raise forensic science standards and has suspended an expanded review of FBI testimony across several techniques that have come under question, saying
| Posted: | 5:25 AM on Wednesday |
| Topic: | Science |
| Hits: | 207248 |
| Rating: | 20725 |
| Poster: | DrCaleb |
 'Islamist link' to bomb attack on Borussia Dortmund bus
'Islamist link' to bomb attack on Borussia Dortmund bus
The Borussia Dortmund team bus has been hit by an explosion while carrying the squad to their Champions League quarter-final against Monaco, with one player taken to hospital.
| Posted: | 12:25 AM on Wednesday |
| Topic: | Sports |
| Hits: | 207110 |
| Rating: | 20711 |
| Poster: | N_Fiddledog |
 African migrants sold in Libya 'slave markets', IOM says
African migrants sold in Libya 'slave markets', IOM says
Those with skills would fetch higher prices, the International Organization of Migration says.
| Posted: | 12:23 AM on Wednesday |
| Topic: | Misc World |
| Hits: | 206789 |
| Rating: | 20679 |
| Poster: | N_Fiddledog |
 Night rescue: Sailor plucked from Tokyo Express off St. John's
Night rescue: Sailor plucked from Tokyo Express off St. John's
Captain Matt Neri says sailor was rescued around 12 a.m. Sunday, 450 nautical miles southeast off St. John's. Royal Canadian Air Force pilot Matt Neri says one of the biggest challenges of doing a medevac from a Cormorant helicopter is making sure everyon
| Posted: | 2:04 PM on Tuesday |
| Topic: | Military |
| Hits: | 207273 |
| Rating: | 20727 |
| Poster: | Hyack |
 Plenty at stake as 2017 election campaign begins
Plenty at stake as 2017 election campaign begins
| Posted: | 11:20 AM on Tuesday |
| Topic: | Provincial Politics |
| Hits: | 207168 |
| Rating: | 20717 |
| Poster: | Strutz |
 Edmonton parking enforcement firm waging battle with police over use of Denver Boot
Edmonton parking enforcement firm waging battle with police over use of Denver Boot
A wheel immobilization device known as the Denver Boot is at the heart of a brewing legal battle between police in Edmonton and a private parking enforcement firm. The company's owners have been jailed, their vehicles impounded and boots seized by police,
| Posted: | 7:04 AM on Tuesday |
| Topic: | Law & Order |
| Hits: | 207542 |
| Rating: | 20754 |
| Poster: | DrCaleb |
 New York poised to pass free public college tuition statewide
New York poised to pass free public college tuition statewide
New York is poised to become the first state in the nation to provide free tuition to public colleges and universities, after a deal struck Friday night.
| Posted: | 11:47 AM on Monday |
| Topic: | Uncle Sam |
| Hits: | 207200 |
| Rating: | 20720 |
| Poster: | N_Fiddledog |
 Multiple shot at San Bernardino elementary school: official
Multiple shot at San Bernardino elementary school: official
A fire official says multiple people have been shot at an elementary school in San Bernardino, Calif.
| Posted: | 11:26 AM on Monday |
| Topic: | Uncle Sam |
| Hits: | 207175 |
| Rating: | 20718 |
| Poster: | Strutz |
 United Airlines forcibly removes passenger from overbooked flight
United Airlines forcibly removes passenger from overbooked flight
A man was forcibly removed from a United Airlines flight from Chicago to Louisville, Ky., on Sunday, after the flight was overbooked and the passenger refused to adhere to the airline's decision to randomly remove four passengers.
| Posted: | 10:44 AM on Monday |
| Topic: | Business |
| Hits: | 207697 |
| Rating: | 20770 |
| Poster: | Strutz |
 Chechnya 'opens first concentration camp for homosexuals'
Chechnya 'opens first concentration camp for homosexuals'
Chechyna, under president Razman Kadyrov, has opened the first concentration camp for homosexuals since Hitler where gay men are being tortured with electric shocks.
| Posted: | 10:24 AM on Monday |
| Topic: | Misc World |
| Hits: | 207014 |
| Rating: | 20701 |
| Poster: | N_Fiddledog |
 Vancouver Canucks fire head coach Willie Desjardins
Vancouver Canucks fire head coach Willie Desjardins
After a dismal season, the Vancouver Canucks have fired head coach Willie Desjardins.
| Posted: | 10:06 AM on Monday |
| Topic: | Sports |
| Hits: | 207531 |
| Rating: | 20753 |
| Poster: | Strutz |
 30,000 litres of fuel spilled at Agnico Eagle facility near Rankin Inlet, Nunavut
30,000 litres of fuel spilled at Agnico Eagle facility near Rankin Inlet, Nunavut
A fuel hose leaked 30,000 litres of diesel fuel at a gold mine in the Kivalliq region of Nunavut. The hose was connected to a 100,000-litre diesel storage tank.
| Posted: | 10:29 PM on Sunday |
| Topic: | Environmental |
| Hits: | 207179 |
| Rating: | 20719 |
| Poster: | Hyack |
 Canada's Hinchcliffe grabs 1st victory since near-fatal 2015 accident
Canada's Hinchcliffe grabs 1st victory since near-fatal 2015 accident
Canada's James Hinchcliffe raced to his first victory since his near-fatal accident in 2015 by hanging on for a three-lap shootout to the finish Sunday on the streets of Long Beach.
| Posted: | 10:28 PM on Sunday |
| Topic: | Sports |
| Hits: | 207362 |
| Rating: | 20737 |
| Poster: | Hyack |
 Bodies of 5 missing hikers recovered near Lions Bay, B.C.
Bodies of 5 missing hikers recovered near Lions Bay, B.C.
Search and rescue workers have recovered the bodies of five hikers who went missing on Saturday after a cornice collapsed on the peak of Mount Harvey in southwestern B.C., sending them tumbling down the mountain's north face.
| Posted: | 10:26 PM on Sunday |
| Topic: | Misc CDN |
| Hits: | 206663 |
| Rating: | 20666 |
| Poster: | Hyack |
 Janet Jackson 'splits from husband Wissam Al Mana'
Janet Jackson 'splits from husband Wissam Al Mana'
Janet Jackson has reportedly split from her husband Wissam Al Mana, just a few months after they welcomed their son Eissa, together on January 3, 2017, but it has been claimed that their marriage is now over.
| Posted: | 1:33 AM on Sunday |
| Topic: | Arts & Entertainment |
| Hits: | 207286 |
| Rating: | 20729 |
| Poster: | N_Fiddledog |
 Could Scotland leave the UK and join CANADA'
Could Scotland leave the UK and join CANADA'
Ken McGoogan, who wrote How the Scots Invented Canada, said that geographical boundaries could be irrelevant so Scotland should find its new home with Canada.
| Posted: | 1:56 PM on Saturday |
| Topic: | Funny |
| Hits: | 208190 |
| Rating: | 20819 |
| Poster: | N_Fiddledog |
 US regulators accuse Google of underpaying female workers
US regulators accuse Google of underpaying female workers
Government investigators looking into how Google pays its employees have accused the tech giant of shortchanging women doing similar work to men.
| Posted: | 10:56 AM on Saturday |
| Topic: | Business |
| Hits: | 206998 |
| Rating: | 20700 |
| Poster: | N_Fiddledog |
 U.S. beats Canada 3-2 in overtime to capture women's hockey gold
U.S. beats Canada 3-2 in overtime to capture women's hockey gold
The United States is still the country to beat in women's hockey. Hilary Knight scored the winner as the Americans downed Canada 3-2 in overtime to capture their fourth straight women's world hockey championship.
| Posted: | 10:52 AM on Saturday |
| Topic: | Sports |
| Hits: | 207300 |
| Rating: | 20730 |
| Poster: | N_Fiddledog |
 Swedish football fans protest mask ban by wearing niqabs
Swedish football fans protest mask ban by wearing niqabs
A group of Swedish football fans have launched a protest against a new ban on wearing masks at stadiums, exploiting an exception to the ban by wearing niqabs to cover their faces.
| Posted: | 9:45 AM on Saturday |
| Topic: | Sports |
| Hits: | 207271 |
| Rating: | 20727 |
| Poster: | N_Fiddledog |
 The Target boycott blindsided the CEO
The Target boycott blindsided the CEO
Target CEO Brian Cornell never approved the post announcing Target's bathroom policy, and he found out about it only after it was published.
| Posted: | 9:32 AM on Saturday |
| Topic: | Business |
| Hits: | 207092 |
| Rating: | 20709 |
| Poster: | N_Fiddledog |
 Ice core samples used for climate change research melted after freezer failure
Ice core samples used for climate change research melted after freezer failure
A freezer malfunction at the University of Alberta has melted some of the world's largest collection of Canadian Arctic ice core samples.
| Posted: | 9:20 AM on Saturday |
| Topic: | Science |
| Hits: | 207387 |
| Rating: | 20739 |
| Poster: | N_Fiddledog |
 Alleged hate crime, arson under investigation in east Charlotte
Alleged hate crime, arson under investigation in east Charlotte
Police in east Charlotte are actively searching for a man accused of lighting an arson fire and leaving behind a disturbing note. Police say the letter was signed White America, but the suspect is a black man.
| Posted: | 9:17 AM on Saturday |
| Topic: | Law & Order |
| Hits: | 206807 |
| Rating: | 20681 |
| Poster: | N_Fiddledog |
 Epic twist reunites enemy soldiers bonded by mercy-act 20 years ago
Epic twist reunites enemy soldiers bonded by mercy-act 20 years ago
Zahed Haftland was 13 when he joined the Iranian army, after fleeing Tehran, only to find himself forced onto the frontlines, facing orders to kill a stranger.
| Posted: | 1:31 PM on Friday |
| Topic: | Military |
| Hits: | 207172 |
| Rating: | 20717 |
| Poster: | Robair |
 Bank of Canada unveils new $10 banknote for Canada 150 celebrations
Bank of Canada unveils new $10 banknote for Canada 150 celebrations
The Bank of Canada has unveiled a new $10 banknote to commemorate the 150th anniversary of Confederation.
| Posted: | 11:47 AM on Friday |
| Topic: | Misc CDN |
| Hits: | 207289 |
| Rating: | 20729 |
| Poster: | DrCaleb |
 Neil Gorsuch Confirmed to Supreme Court After Senate Uses 'Nuclear Option'
Neil Gorsuch Confirmed to Supreme Court After Senate Uses 'Nuclear Option'
The Senate confirmed judge Neil Gorsuch to the Supreme Court Friday in a mostly party-line vote that reflected weeks of bruising political fighting.
| Posted: | 9:36 AM on Friday |
| Topic: | Uncle Sam |
| Hits: | 207090 |
| Rating: | 20709 |
| Poster: | N_Fiddledog |
 Food expert raises concerns that garlic powder may contain inferior ingredients
Food expert raises concerns that garlic powder may contain inferior ingredients
One of the world's foremost experts on food fraud is warning about the possibility that garlic powder on store shelves including those in Canada may contain inferior ingredients.
| Posted: | 8:23 AM on Friday |
| Topic: | Health |
| Hits: | 207463 |
| Rating: | 20746 |
| Poster: | DrCaleb |
 Stockholm terror attack: Truck rams into people in Sweden
Stockholm terror attack: Truck rams into people in Sweden
At least five people are believed to have been killed when a truck crashed into shoppers in Stockholm.
| Posted: | 7:33 AM on Friday |
| Topic: | Misc World |
| Hits: | 207128 |
| Rating: | 20713 |
| Poster: | martin14 |
 B.C. reinstates ferry route between Port Hardy, mid-coast communities
B.C. reinstates ferry route between Port Hardy, mid-coast communities
Four years after BC Ferries cut service between Port Hardy and Bella Coola, the service says it's buying a used vessel in order to begin another run between the two communities.
| Posted: | 7:58 PM on Thursday |
| Topic: | Misc CDN |
| Hits: | 207126 |
| Rating: | 20713 |
| Poster: | Hyack |
 Greyhound passengers stranded, cold and frustrated after bus catches fire
Greyhound passengers stranded, cold and frustrated after bus catches fire
About 20 Greyhound bus passengers spent a chilly morning stranded on the highway outside of Cache Creek B.C. after their bus caught fire.
| Posted: | 7:56 PM on Thursday |
| Topic: | Misc CDN |
| Hits: | 207197 |
| Rating: | 20720 |
| Poster: | Hyack |
The comments are property of their posters, all the rest © 2025 by Canadaka.net

